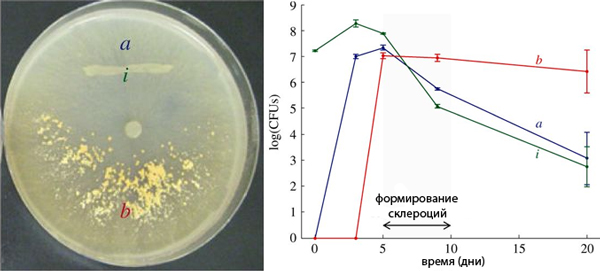
В чашке Петри хорошо видны склероции в виде скопления желтых зерен

Европейские ученые исследовали симбиотические отношения между грибами и почвенными бактериями. Эту тривиальную задачу они решали с помощью оценки потоков веществ от грибов к бактериям и от бактерий к грибам на разных стадиях жизненного цикла грибов, получив в итоге совсем нетривиальный результат. Оказалось, что взаимодействие грибов и бактерий очень напоминает сельскохозяйственную практику. Грибы выращивают рядом с собой определенную бактериальную монокультуру, подкармливают ее, собирают урожай, сохраняя его в специальных местах, да еще и запасаются «рассадой» для следующих посевов. Этот подход к толкованию симбиотических отношений среди низших организмов существенно обогащает наши представления и о собственной земледельческой деятельности, и об эволюции симбиоза у грибов и бактерий.
Среди эукариот известны всего несколько видов, которые для своих пищевых нужд выращивают те или иные урожайные культуры. Кроме человека, который около 10–11 тысяч лет назад перешел от сбора к производству съедобных растений (см. Пшеница не сразу окультурилась, «Элементы», 06.04.2006), сельским хозяйством занимаются рыбки, муравьи, термиты и жуки-короеды. Излюбленной культурой для муравьев и жуков являются грибы (см. Муравьи используют азотные удобрения для своих угодий, «Элементы», 23.11.2009). Они ухаживают за своими посевами, удобряют их, защищают от вредителей и болезней, при переселении засаживают новые делянки запасенными спорами. Но как выясняется, грибы могут выступать не только в роли пищевой культуры, но и сами становятся прилежными агрономами, выращивая для своего пропитания почвенных бактерий. Они подкармливают свои огороды питательными веществами, а потом используют урожай в качестве легко усваиваемой органики, да еще и запасаются семенами для производства следующих урожаев. Чем не сельское хозяйство!
К таким выводам пришли исследователи из Лозаннского университета и Университета Невшателя (Швейцария), а также из Центра исследований окружающей среды Гельмгольца в Лейпциге (Германия). Они задались вполне тривиальным вопросом: что получают грибы от почвенных бактерий? С одной стороны, на этот вопрос вроде бы существует ясный ответ: бактерии фиксируют азот, некоторые фотосинтезируют и тем самым доставляют своим сожителям органический углерод; бактерии, в свою очередь, используют грибные гифы в качестве удобных транспортных магистралей, «скоростных шоссе», по которым можно быстро добраться до влажных мест. Однако ученые решили всё же экспериментально оценить выгоду, которую получают от бактерий грибы (таких оценок до сих пор не существовало). И вот, в ходе этих довольно простых и, на первый взгляд, малообещающих экспериментов открылась целая сельскохозяйственная система, которую, как выяснилось, организовали для себя грибы.

Рис. 2. Клетки бактерий Pseudomonas putida (зеленые точки) на грибных гифах. Фото из обсуждаемой статьи в Proceedings of the Royal Society B
Модельными объектами были выбраны Morchella crassipes, или сморчки (да-да, те самые, которые так прекрасны теплым майским вечером со сметаной!), и их неизменные спутники почвенные бактерии Pseudomonas putida. Последние для лучшей визуализации снабдили зеленой флуоресцирующей меткой.
И вот в культуру сморчков добавили бактерий, всего одну каплю. Бактерии расселились не на агаре, а устроились вдоль грибных гиф.
Бактерии использовали грибные транспортные магистрали, заполняя пространство в 6 раз активнее, чем чистые культуры без грибов. Но удобство и скорость расселения — это еще не всё. Бактерии, как выяснилось, росли на выделениях грибных гиф, перерабатывая их для своего питания. Иными словами, грибы поселили бактериальную монокультуру в непосредственной от себя близости и обеспечили ее питательными веществами. Ученые сравнили этот процесс со стадией посадки и проращивания семян в привычной для нас аграрной терминологии.
Через 5–7 дней грибы начали образовывать склероции – особые тела с плотными оболочками, спорами и концентратом питательных веществ. Так грибы заготовили себе запасы пищи на черный день, приготовившись переживать неблагоприятные времена. И в этих запасах оказалась синтезированная бактериями органика!
Это доказали двумя путями. Во-первых, определили количество бактериальных клеток вокруг склероциев и в отдалении от них. Во время формирования склероциев изначально равная плотность бактериальных клеток резко снизилась в отдаленной от склероциев зоне (см. график на рис. 3). Как показали дополнительные эксперименты, это объяснялось транспортировкой бактериальной органики из отдаленных зон в зону склероциев. Во-вторых, ученые с помощью радиоактивных меток у бактерий показали резкое, в полтора раза, повышение количества бактериальной органики внутри склероциев. Получается, что во время формирования склероциев грибы собирали произведенную бактериями органику и отправляли ее на хранение в свои покоящиеся тела. Эту стадию ученые сопоставляют с уборкой урожая и организацией хранилищ.
Рис. 3. В чашке Петри хорошо видны склероции в виде скопления желтых зерен в области b. Полосочка i — это место изначальной бактериальной затравки в грибную культуру. График справа отражает показатель количества бактериальных клеток в трех зонах чашки Петри: в зоне склероций (b), в зоне изначальной затравки (i) и около нее (a). Рисунок из обсуждаемой статьи в Proceedings of the Royal Society B
В этих хранилищах оказались не только органические вещества и споры гриба, там еще законсервировались и сами бактерии. Если пересадить склероций в новую стерильную среду, то и здесь на гифах поселятся те же самые бактерии. И цикл выращивания и сбора урожая в склероции начнется снова.
Грибы могут культивировать не только этот конкретный вид бактерий, Pseudomonas putida, но и другой, Pseudomonas knackmusii. Он тоже распространяется по гифам, увеличивает свою численность, и в конечном итоге наработанные им органические вещества и сами бактериальные клетки передаются грибу. А вот еще один испытанный учеными вид, Cupriavidus necator, использует все преимущества сожительства с грибом, быстро распространяясь вдоль гиф, но гриб, в свою очередь, не может эксплуатировать бактерии себе на пользу. Что ж, человек тоже культивирует не все виды растений, которые встречает, хотя многие растения расселяются так или иначе вместе с человеком.
Таким образом, если присмотреться внимательнее к этому случаю взаимовыгодного сотрудничества двух видов — гриба и бактерии, — то неизбежно возникают аналогии с сельским хозяйством. Ведь было странно даже подумать о том, что интенсивный способ добычи пропитания, который человек считает одним из своих главных культурных достижений, был опробован задолго до появления человека, млекопитающих, позвоночных и даже вообще животных. Этот пример заставляет нас по-новому взглянуть на сущность земледелия с биологической и эволюционной точки зрения. Вполне возможно, что в ближайшем будущем найдутся и другие примеры «земледелия» среди самых разных групп живых существ и понятие «земледелие» будет существенно расширено. Важно при этом точно определить, каким критериям оно должно удовлетворять.
Источник: Martin Pion, Jorge E. Spangenberg, Anaele Simon, Saskia Bindschedler, Coralie Flury, Auriel Chatelain, Redouan Bshary, Daniel Job, Pilar Junier. Bacterial farming by the fungus Morchella crassipes // Proc. R. Soc. B. 2013. V. 280. P. 20132242. DOI:10.1098/rspb.2013.2242. Published 30 October 2013.
См. также:
Hiroki Hata, Makoto Kato. A novel obligate cultivation mutualism between damselfish and Polysiphonia algae // Biol. Lett. 22 December 2006. V. 2. № 4. P. 593–596. (О том, как рыбки выращивают себе урожай водорослей, то есть от охоты и собирательства переключаются на интенсивное растениеводство.)
Елена Наймарк




Рис. 1. Темный стегастес (Stegastes nigricans) на своей делянке: рыбка высаживает споры или фрагменты водорослей на подходящий грунт, отгоняет от посевов желающих пообедать, выпалывает сорняки, иначе посевы быстро зарастут макрофитами, — чем не растениеводство? Это пока единственный известный пример окультуривания видов в естественной морской среде. Теперь ученые настаивают на существовании сельскохозяйственной практики даже у грибов. Фото с сайта www.nbcnews.com